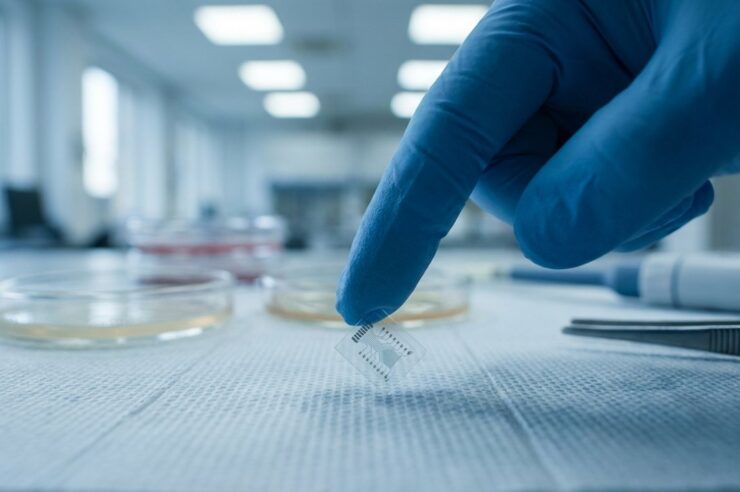
Cortical Labs รันโค้ดบนเซลล์สมองมนุษย์จริง ดาต้าเซ็นเตอร์ชีวภาพแห่งแรกกำลังจะมา

สรุปข่าว
- Cortical Labs บริษัทเทคโนโลยีชีวภาพจากออสเตรเลีย พัฒนาคอมพิวเตอร์ชีวภาพที่ใช้เซลล์สมองมนุษย์จริงเป็นฮาร์ดแวร์คำนวณ ผ่านอุปกรณ์ชื่อ CL1
- ล่าสุดในช่วงต้นปี 2026 เซลล์สมองมนุษย์ราว 200,000 เซลล์บนไมโครชิปสามารถเล่นเกม Doom ได้สำเร็จ และบริษัทประกาศแผนสร้างดาต้าเซ็นเตอร์ชีวภาพแห่งแรกในสิงคโปร์และออสเตรเลีย
- เทคโนโลยีนี้อาจเป็นทางออกของวิกฤตพลังงาน AI โดยบริษัทอ้างว่าคอมพิวเตอร์ชีวภาพใช้พลังงานน้อยกว่าซิลิกอนแบบดั้งเดิมได้ถึง 100,000 เท่า
แนวโน้มผลกระทบต่อราคา Neutral
ข่าวนี้เป็นความก้าวหน้าด้านเทคโนโลยี AI และการประมวลผลเชิงชีวภาพ ซึ่งไม่มีผลกระทบโดยตรงต่อราคาสินทรัพย์คริปโตในระยะสั้น แต่ในระยะยาวอาจส่งผลต่อภูมิทัศน์ของโครงสร้างพื้นฐาน AI และดาต้าเซ็นเตอร์ที่เชื่อมโยงกับโลกบล็อกเชน
เทคโนโลยีที่ฟังดูเหมือนนิยายวิทยาศาสตร์กลายเป็นความจริงแล้ว ตามรายงานจาก Cointelegraph Cortical Labs บริษัทเทคโนโลยีชีวภาพสัญชาติออสเตรเลียที่ก่อตั้งในปี 2019 ได้พัฒนาระบบที่ใช้เซลล์สมองมนุษย์จริงเป็นฮาร์ดแวร์คำนวณ โดยอุปกรณ์ที่เรียกว่า CL1 นั้นบรรจุเซลล์ประสาทที่เพาะเลี้ยงในห้องทดลองไว้บนแผ่นวงจรอิเล็กโทรด พร้อมระบบหล่อเลี้ยงชีวิตภายในที่ช่วยให้เซลล์อยู่รอดได้นานถึง 6 เดือน ในช่วงต้นปี 2026 ทีมงานสามารถรันเกม Doom บนเซลล์สมองมนุษย์ราว 200,000 เซลล์ได้สำเร็จเป็นครั้งแรก และล่าสุดบริษัทได้ประกาศจับมือกับ DayOne เพื่อสร้างดาต้าเซ็นเตอร์ชีวภาพแห่งแรกในสิงคโปร์และออสเตรเลีย
จากเล่นเกม Pong สู่ Doom บนเซลล์สมองมนุษย์
การพัฒนาของ Cortical Labs เริ่มต้นจากระบบที่เรียกว่า DishBrain ซึ่งถูกตีพิมพ์ในวารสาร Neuron เมื่อเดือนตุลาคม 2022 โดยระบบดังกล่าวใช้เซลล์ประสาทจากมนุษย์และหนูรวมกันราว 800,000 เซลล์เพื่อเล่นเกม Pong ในสภาพแวดล้อมแบบวนซ้ำแบบ real-time นับเป็นครั้งแรกที่โลกเห็นว่าเซลล์สมองสามารถ “เรียนรู้” และตอบสนองต่อสัญญาณไฟฟ้าในลักษณะที่มีเป้าหมายได้
ก้าวกระโดดครั้งใหญ่เกิดขึ้นในช่วงกุมภาพันธ์ถึงมีนาคม 2026 เมื่อ Dr. Alon Loeffler และ Sean Cole สามารถเขียนโค้ดรุ่นแรกของเกม Doom ที่ทำงานได้จริงบนอุปกรณ์ CL1 โดยเซลล์สมองที่ใช้ส่วนใหญ่มาจาก Hon Weng Chong ซีอีโอของบริษัทเอง ซึ่งบริจาคเลือดเพื่อให้นำเม็ดเลือดขาวมาตั้งต้นพัฒนาเป็นเซลล์สมอง ข้อสำคัญคือ “การรันโค้ด” ในที่นี้ไม่ใช่การเขียนโปรแกรมแบบดั้งเดิม แต่คือการแปลสัญญาณไฟฟ้าผ่านระบบปฏิบัติการชีวภาพ (biOS) และ API ที่ Cortical Labs พัฒนาขึ้นเพื่อสื่อสารกับเซลล์ประสาท
ดาต้าเซ็นเตอร์ชีวภาพกับคำตอบของวิกฤตพลังงาน AI
ในเดือนมีนาคม 2026 Cortical Labs ประกาศจับมือกับ DayOne บริษัทพัฒนาดาต้าเซ็นเตอร์สัญชาติสิงคโปร์ เพื่อสร้างดาต้าเซ็นเตอร์ชีวภาพแห่งแรกในสิงคโปร์และออสเตรเลีย โดยมุ่งเป้าไปที่การแก้ปัญหาวิกฤตพลังงานของ AI ที่กำลังทวีความรุนแรง บริษัทระบุว่าคอมพิวเตอร์ชีวภาพอาจใช้พลังงานน้อยกว่าระบบซิลิกอนแบบดั้งเดิมได้สูงถึง 100,000 เท่า และอาจใช้พลังงานน้อยกว่าเครื่องคิดเลขเสียอีก ปัจจุบัน CL1 วางจำหน่ายแล้วในราคาประมาณ 35,000 ดอลลาร์ต่อเครื่อง พร้อมบริการ Cortical Cloud ที่ให้ผู้ใช้เข้าถึงเครือข่ายประสาทชีวภาพจากระยะไกลผ่าน Python SDK ในรูปแบบ Wetware-as-a-Service (WaaS)
ก่อนหน้านี้ Siam Blockchain ได้รายงานว่า เซลล์สมองมนุษย์ถูกเชื่อมต่อกับ AI เป็นครั้งแรกของโลก ซึ่งเป็นการรายงานเรื่อง CL1 ในช่วงต้นเดือนมีนาคม 2026 ซึ่งสอดคล้องกับทิศทางการพัฒนาของ Cortical Labs ที่เดินหน้าอย่างต่อเนื่อง
ส่วนตัวผู้เขียนมองว่าเรื่องนี้น่าสนใจมากในฐานะเทคโนโลยี แต่ยังต้องติดตามอีกนาน เพราะระหว่างที่เซลล์สมองเล่น Doom ได้กับการนำมาใช้งานจริงในดาต้าเซ็นเตอร์เชิงพาณิชย์ขนาดใหญ่นั้นเป็นคนละเรื่องกันมาก ประเด็นที่น่าจับตามองมากกว่าคือมิติจริยธรรม เพราะการใช้เซลล์สมองมนุษย์เป็นฮาร์ดแวร์นั้นยังมีคำถามหลายข้อที่ยังไม่มีคำตอบที่ชัดเจน แต่ถ้า Cortical Labs พิสูจน์ได้จริงว่าระบบนี้ประหยัดพลังงานได้มากขนาดนั้น อาจพลิกโฉมวิธีที่โลกมองโครงสร้างพื้นฐาน AI ไปเลยก็ได้
ที่มา: @Cointelegraph
ภาพจาก AI